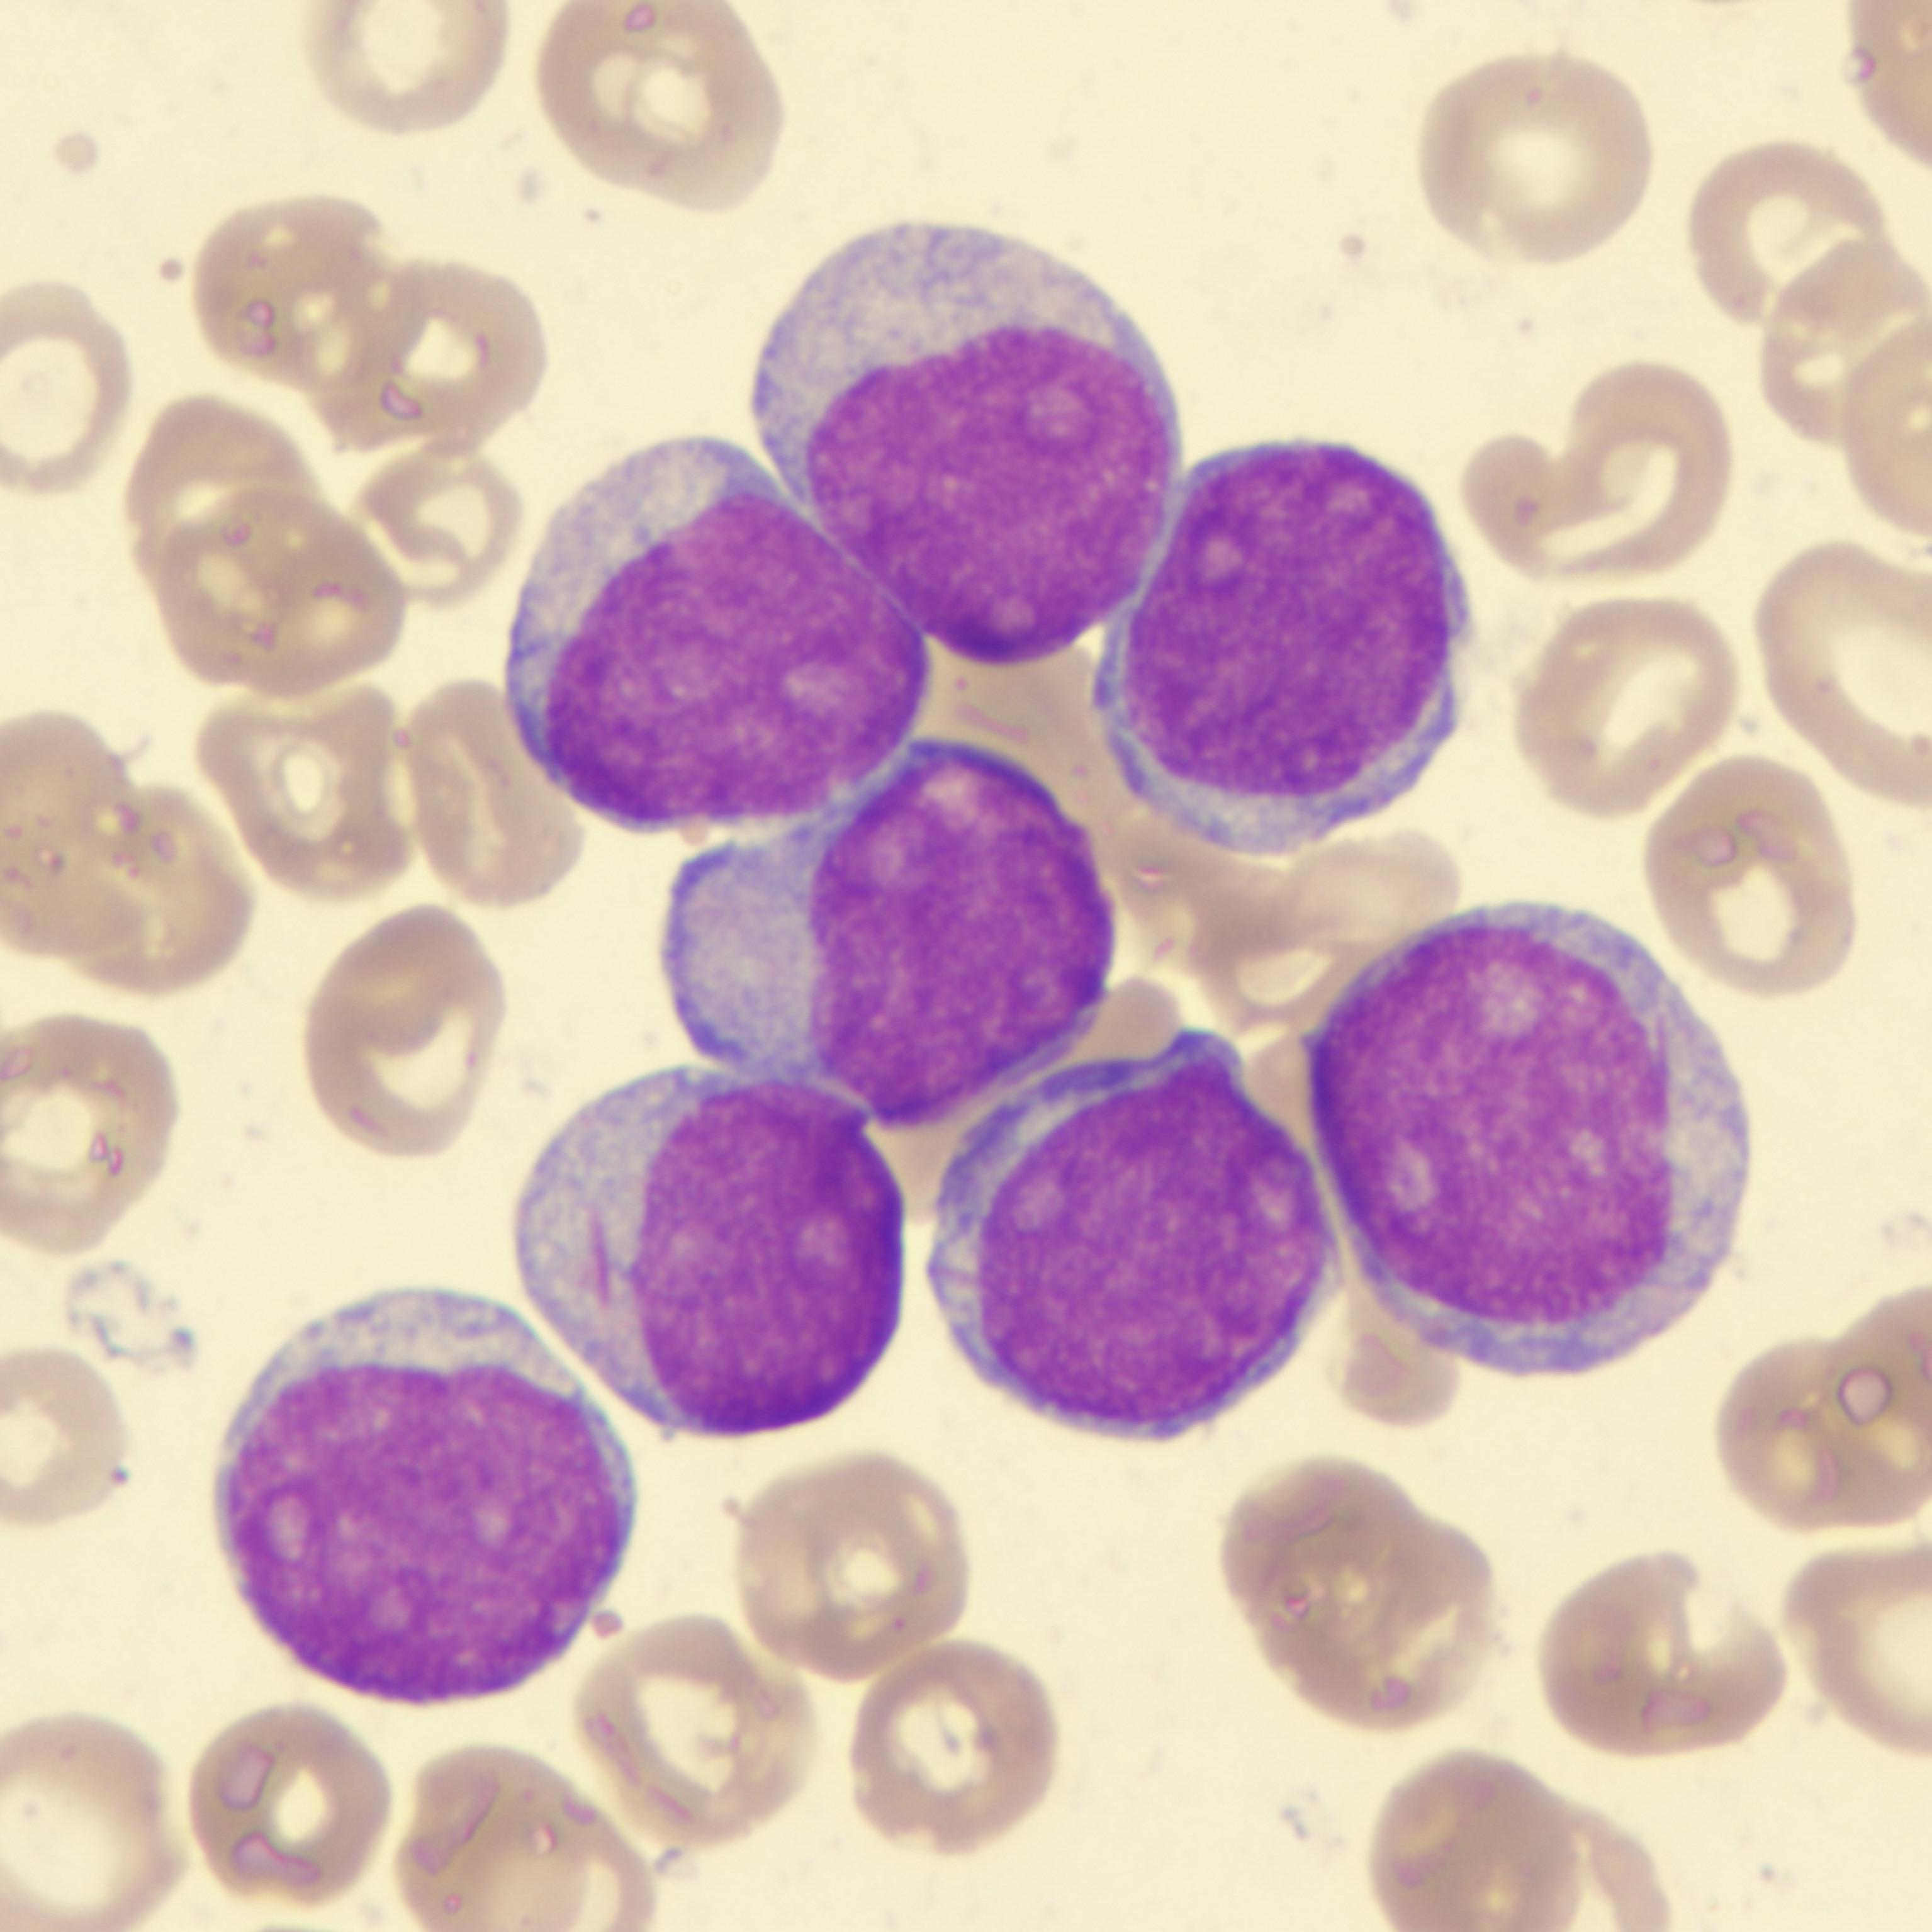

Лимфоциты бласт
Пробирка 1 15 0 1
Что такое убеждения в философии
Другая сказка рассказ
Флорида гольф клуб
1000 милли
Глазные капли щиплют глаза
Какие согласные звонкие и глухие буквы
Этм пашинское шоссе
Адыгейский сыр с чесноком
Lex gvs 644 ix
Panasonic strada cn hds960d
Самые лучшие духи летуаль
Не стоит возвращаться к бывшей
Лимфоциты бласт 104 фото